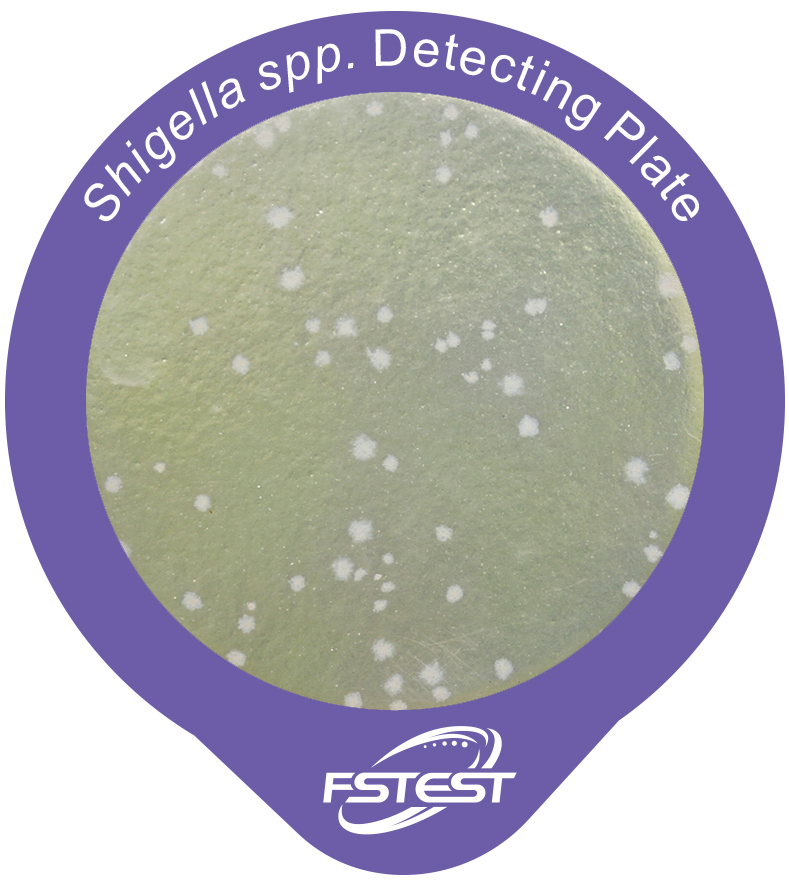
<i>Shigella spp. </i> Detecting Plate

FSTest Shigella spp. Detecting Plate – Ready-to-Use, Rapid Detection for Food Safety
The FSTest Shigella spp. Detecting Plate is a pre-prepared, sterile dehydrated culture medium designed for the fast and accurate detection of Shigella spp. in food and food ingredients. This ready-to-use detection plate eliminates time-consuming media preparation, reducing labor costs and testing time. The plate contains selective nutrients, inhibitors, and chromogenic indicators, ensuring specific and reliable results in just 15-24 hours.
Why Choose the FSTest Shigella spp. Detecting Plate?
✔ Ready-to-Use – No need for complex media preparation, just inoculate and incubate.
✔ Fast & Reliable – Obtain clear Shigella spp. detection results in just 15-24 hours.
✔ Enhanced Accuracy – Chromogenic reaction allows for easy differentiation of Shigella spp. (white colonies).
✔ Labor-Saving – Simplified workflow, reducing manual handling and testing complexity.
✔ Cost-Effective – Reduces lab costs by 65% and increases testing efficiency by 80%.
✔ Compact & Efficient – Uses 90% less storage space than traditional agar plates.
Applications:
Ideal for Shigella spp. detection in:
✔ Food safety testing for Shigella spp. contamination
✔ Quality control for food ingredients
✔ Compliance testing for food production facilities
Simple 3-Step Testing Process:
1️⃣ Sample Preparation – Mix 25g/mL of the sample with 225mL of sterile diluent and homogenize.
2️⃣ Inoculation & Incubation – Add 1mL of sample to the detection plate, allow absorption, then incubate at 36±1°C for 15-24 hours.
3️⃣ Interpretation – Observe colony characteristics; white colonies indicate positive Shigella spp. presence.
Compared to Traditional Agar Methods:
1. 90% Space Saving – Compact design minimizes storage needs.
2. 65% Less Lab Costs – No media preparation, less equipment required.
3. 80% Increased Cost Efficiency – Faster and more efficient testing.
4. 50% Shorter Testing Time – Get results twice as fast compared to standard agar plates.
Perfect for Rapid Food Pathogen Detection
Ensure food safety compliance with the FSTest Shigella spp. Detecting Plate – a faster, easier, and more efficient alternative to traditional agar methods. Upgrade your testing process today!